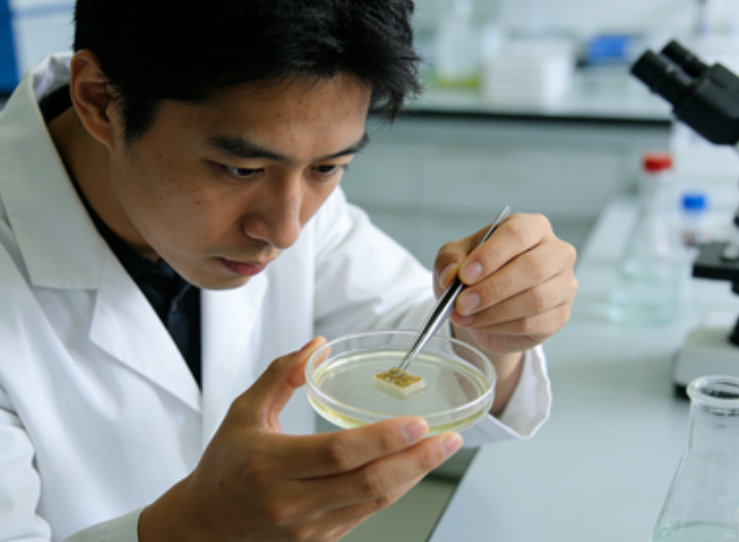

EMSA实验的重复性差,如何从试剂、操作步骤等方面进行优化?
EMSA(电泳迁移率变动分析)实验重复性差,核心问题往往出在试剂稳定性控制和操作步骤的标准化上,以下是针对性的优化方案:
一、试剂层面的优化:保证试剂活性与浓度一致性
EMSA对蛋白、探针、缓冲液的稳定性和浓度非常敏感,这是实验重复的基础。
1、探针的制备与保存优化
(1)探针标记与纯化:
采用高比活度的同位素标记(如³²P)或荧光标记,标记后必须通过聚丙烯酰胺凝胶电泳(PAGE)或离心柱纯化,去除未结合的核苷酸,避免游离标记物干扰条带信号。
若为非标记探针,需通过紫外分光光度计准确定量,确保每次实验探针浓度一致(通常终浓度1–10nmol/L)。
(2)探针保存:
标记后的探针分装成小体积(如5–10μL/管),-20℃避光保存,避免反复冻融导致探针降解或断裂;非标记探针可-20℃长期保存,使用前室温溶解并短暂离心。
避免探针在室温放置过久,防止单链探针形成二级结构或双链探针解链。
2、蛋白样品的稳定性控制
(1)蛋白提取与分装:
核蛋白或重组蛋白提取时,全程在冰上操作,使用预冷的裂解液和离心管;提取后立即分装,-80℃保存,严禁反复冻融(反复冻融会导致蛋白聚合、活性丧失)。
每次实验取用同一批次的蛋白,且用BCA或Bradford法准确定量,确保每次上样的蛋白浓度完全一致。
(2)蛋白活性保护:
结合反应缓冲液中添加甘油(终浓度5%–10%)、BSA(0.1–0.5mg/mL)或蛋白酶抑制剂,防止蛋白变性;核蛋白还需添加Mg²⁺、K⁺等阳离子,维持其与DNA结合的活性构象。
若蛋白活性易丧失,可在冰上完成结合反应,缩短反应时间。
3、缓冲液的配制与保存优化
(1)缓冲液配制:
所有缓冲液(结合缓冲液、电泳缓冲液)均使用超纯水配制,避免离子杂质干扰;结合缓冲液的pH需精准调至7.5–8.0(根据蛋白特性调整),离子强度(如NaCl浓度)需保持一致,过高会抑制蛋白-DNA结合,过低会增加非特异性结合。
电泳缓冲液(如0.5×TBE)需现配现用,或4℃避光保存,避免反复使用导致离子强度下降、pH改变。
(2)添加剂的使用:
结合反应中添加非特异性竞争DNA(如鲑鱼精DNA、poly(dI-dC)),且每次实验用量严格一致(通常50–200ng/反应),过量会抑制特异性结合,不足则无法有效封闭非特异性位点。
二、操作步骤的标准化:减少人为误差
EMSA的操作步骤环环相扣,任何一个环节的细微差异都会影响重复性,需严格制定标准操作流程(SOP)。
1、结合反应的标准化操作
(1)反应体系的配制顺序:
严格遵循“缓冲液→水→竞争DNA→蛋白→探针”的加样顺序,先让蛋白与竞争DNA充分结合封闭非特异性位点,再加入探针进行特异性结合,避免探针先与蛋白发生非特异性结合。
(2)反应条件的严格控制:
结合反应的温度和时间固定:通常室温(20–25℃)反应20–30min,或4℃反应30–60min(根据蛋白特性),每次实验时间误差不超过5min。
反应体系混匀时,采用轻柔吹打或指尖轻弹管壁,避免剧烈涡旋导致蛋白-DNA复合物解离。
(3)上样前的处理:
反应结束后立即加入上样缓冲液(不含SDS和尿素等变性剂),轻轻混匀后立即上样,避免复合物在室温放置过久解离。
2、电泳过程的一致性控制
(1)凝胶制备的标准化:
丙烯酰胺凝胶的浓度固定(通常4%–6%的非变性PAGE),APS和TEMED的用量精准,灌胶后室温聚合30–60min,确保凝胶孔径均一;每次使用同一批次的丙烯酰胺和双丙烯酰胺,避免批次差异。
凝胶制备后4℃预冷30min,电泳全程在4℃低温下进行,防止温度过高导致蛋白-DNA复合物解离,同时避免凝胶发热变形。
(2)电泳参数的固定:
采用恒压电泳,电压设置为100–150V(根据凝胶大小调整),电泳时间以溴酚蓝迁移至凝胶1/2–2/3处为宜,每次实验电压和时间完全一致,避免电压波动导致条带迁移率差异。
电泳缓冲液液面需完全没过凝胶,且每次电泳使用新鲜的缓冲液或同一批次预冷的缓冲液。
3、显影/染色步骤的标准化
若为同位素标记探针,显影时曝光时间、温度固定,使用同一批次的显影液和定影液;若为荧光标记,荧光成像仪的参数(激发光强度、曝光时间)保持一致。
若为考马斯亮蓝染色,染色和脱色时间严格固定,避免过度脱色导致条带丢失或染色不均。
三、其他辅助优化措施
实验全程使用无酶枪头和离心管,避免核酸酶污染降解探针。
每次实验设置阳性对照、阴性对照和空白对照:阳性对照验证蛋白结合活性,阴性对照(如突变探针、无蛋白反应)排除非特异性条带干扰,便于结果对比。
同一批次的实验尽量在同一天完成,减少环境因素(如室温、湿度)的波动。
最新动态
-
03.04
RNA合成:RNA体外转录和修饰
-
03.04
rna pull down实验与rip的区别
-
03.04
qRT-PCR引物设计的准则
-
03.04
ChIP-seq染色质免疫沉淀测序技术
-
03.03
在筛选弱亲和力或瞬时相互作用时,平衡态分析的互作试剂盒失效,应如何突破检测极限?
-
03.03
在进行分子互作研究时,如何根据实验需求做出最优的技术选型?
-
02.28
COIP试剂盒里包含哪些关键组分?是否需要自备一抗/二抗?
-
02.28
ATAC-seq标准生信分析流程包含哪些关键步骤?
-
02.28
如何利用ATAC-seq数据推断转录因子结合位点?
-
02.27
蛋白抗体表达服务包含哪些纯化环节?最终交付标准是什么?


